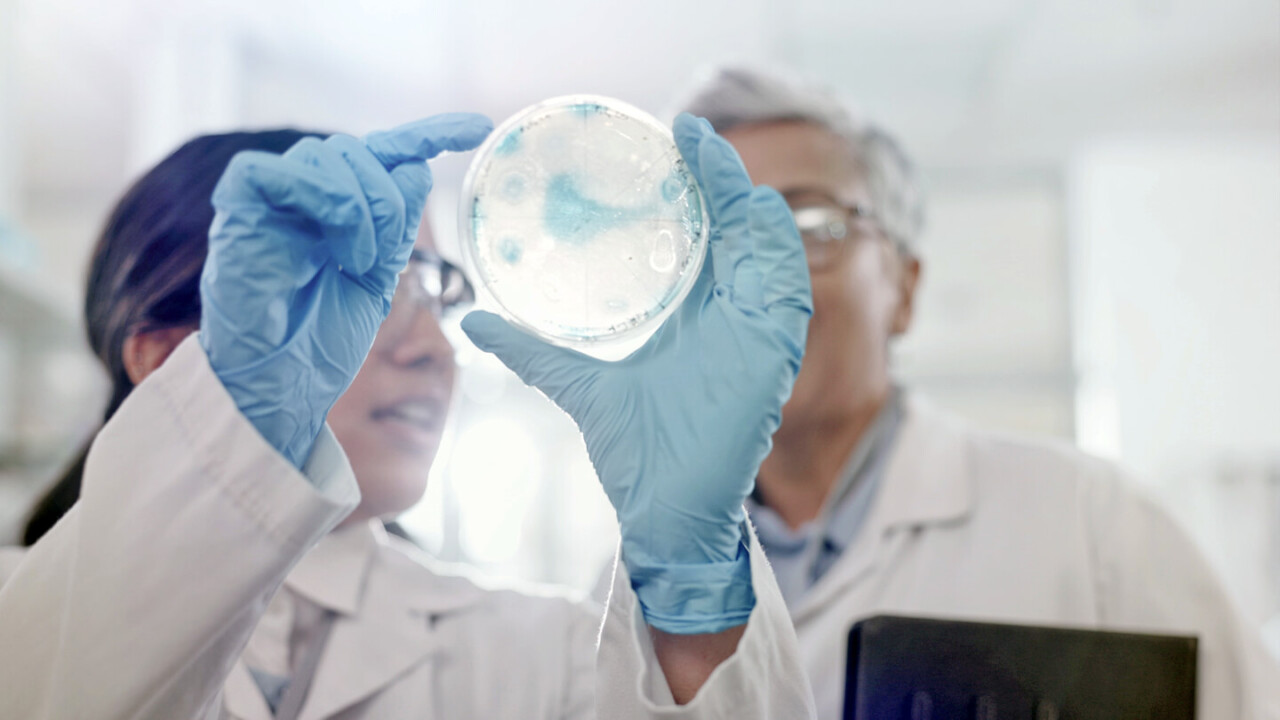
dil-ev-weiterbildung-masterstudiengang-Food-Process-and-Product-Engineering Drei junge Wissenschaftlerinnen im Labor pipettieren Proben und tragen Schutzbrillen – praktische Weiterbildung im Masterstudiengang Food Processing and Product Engineering (FPPE) am DIL e.V.

Institut
Plattform für Innovation
Wissen für innovative Lebensmittel
Das DIL verbindet seit 1983 fundiertes Forschungs-Know-how entlang der gesamten Wertschöpfungskette von Lebensmitteln
Das DIL Deutsches Institut für Lebensmitteltechnik e. V. ist ein außeruniversitäres, gemeinnütziges Forschungsinstitut, das seit seiner Gründung im Jahr 1983 als Innovationsmotor für die Lebensmittelwirtschaft wirkt. In Quakenbrück – im Zentrum der niedersächsischen Lebensmittelindustrie – ist über die letzten Jahrzehnte ein international vernetztes Institut mit rund 120 Expertinnen und Experten aus Lebensmitteltechnologie, Lebensmittelwissenschaft, Analytik, Nachhaltigkeit und Food Data entstanden.
Mit über 150 Mitgliedsunternehmen sowie starken Partnerschaften mit Industrie, Forschungseinrichtungen und Universitäten bildet das DIL eine einzigartige Plattform, die Wissenschaft und Praxis eng miteinander verbindet – immer mit einem klaren Ziel: Innovationen für zirkuläre und resiliente Lebensmittelsysteme voranzutreiben.
Das Institut in Zahlen

Expertinnen & Experten

Abteilungen für Forschung

Mitgliedsunternehmen
Unsere Arbeit umfasst ein breites Spektrum modernster Lebensmitteltechnologien
Im Fokus stehen innovative Prozesse, Produkte und Technologien, die Qualität, Sicherheit und ernährungsphysiologische Wertigkeit von Lebensmitteln nachhaltig verbessern. Dabei untersuchen wir komplexe Zusammenhänge entlang der gesamten Wertschöpfungskette – von Rohstoffen und Inhaltsstoffen über Verarbeitung und Struktur bis hin zu Funktionalität und ernährungsphysiologischer Wirkung im Lebensmittel. Moderne Analytik und experimentelle Forschung ermöglichen es uns, Prozesse gezielt zu verstehen, zu optimieren und weiterzuentwickeln.
Unsere Forschung erfolgt im engen Austausch mit Industriepartnern, Hochschulen und öffentlichen Fördergebern. So stellen wir sicher, dass wissenschaftliche Erkenntnisse praxisnah nutzbar werden und neue Technologien erfolgreich den Weg in die Anwendung finden. Mit interdisziplinären Teams und exzellenter Infrastruktur leisten wir einen aktiven Beitrag zur zukunftsfähigen Gestaltung von Ernährung und Lebensmittelsystemen.
Unsere Forschungsabteilungen
Struktur & Verarbeitung
Nachhaltigkeit
Ein starker Partner der Industrie
Das DIL kombiniert fundierte Forschung mit praxisnaher Umsetzung. Die enge Verzahnung mit den industriellen Partnern ermöglicht einen schnellen Technologietransfer – von der Idee bis zum marktreifen Produkt. Mit modern ausgestatteten Laboren, Technika, Maschinenbaukompetenzen und digitalen Plattformen verfügt das DIL über eine Infrastruktur, die von der Grundlagenforschung bis zur industriellen Pilotfertigung reicht.
Unsere Stärken
- Von der Produkt- und Prozessentwicklung bis zur Markteinführung
- Labore
- Pilotanlagen
- Versuchstechnika
- Aus Wissenschaft, Technik, Analytik und Engineering
- Mit Industriepartnern, Universitäten und Hochschulen
- Und Entrepreneurship
Aus- und Weiterbildung
Am DIL verbinden wir wissenschaftliche Expertise mit praxisnaher Anwendung, um Fachkräfte, Führungskräfte und Studierende gezielt weiterzubilden. Unser Angebot reicht von Workshops, Fachseminaren, Tagungen und Konferenzen über spezialisierte Weiterbildungsprogramme für die Lebens- und Futtermittelbranche bis hin zu akademischen und internationalen Lehrformaten. Dazu zählen das Mischfutterseminar für Fachkräfte der Futtermittelbranche, die Weiterbildung Quality Management Food and Feed für Fach- und Führungskräfte des Qualitätsmanagements sowie der internationale Masterstudiengang Food Process and Product Engineering (M.Sc. FPPE).
Darüber hinaus sind wir mit unserem Kurs Food Technologies an der International Summer University der Hochschule Osnabrück beteiligt und bieten internationalen Studierenden praxisnahe Einblicke in moderne Lebensmitteltechnologien. Neben der Weiterbildung ist das DIL auch Ausbildungsbetrieb und qualifiziert Nachwuchskräfte in verschiedenen Berufsfeldern. Einen Überblick über unsere Ausbildungsangebote finden Sie unter www.dil-ausbildung.de.

Am DIL verbinden wir Wissenschaft und Praxis und schaffen Weiterbildung, die Wissen vertieft, Kompetenzen stärkt und Zukunft gestaltet.
Mehr über unsere Aus- und Weiterbildungen erfahren?